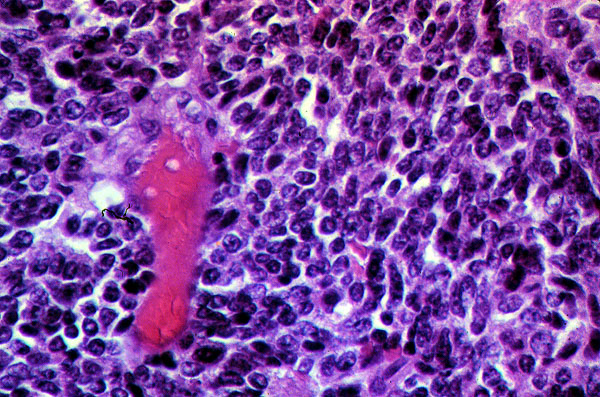

Small cell carcinoma
Click picture to enlarge. Close window to return
This is the typical microscopic appearance of small cell carcinoma. It differs from other tumors by the much smaller size of the cells and scanty amount of cytoplasm. The size of these tumor cells is approximately one and a half to two times the size of a normal lymphocyte. The intermediate type of small cell carcinoma is approximately one and a half to two times the size of the oat cell type of small cell carcinoma.